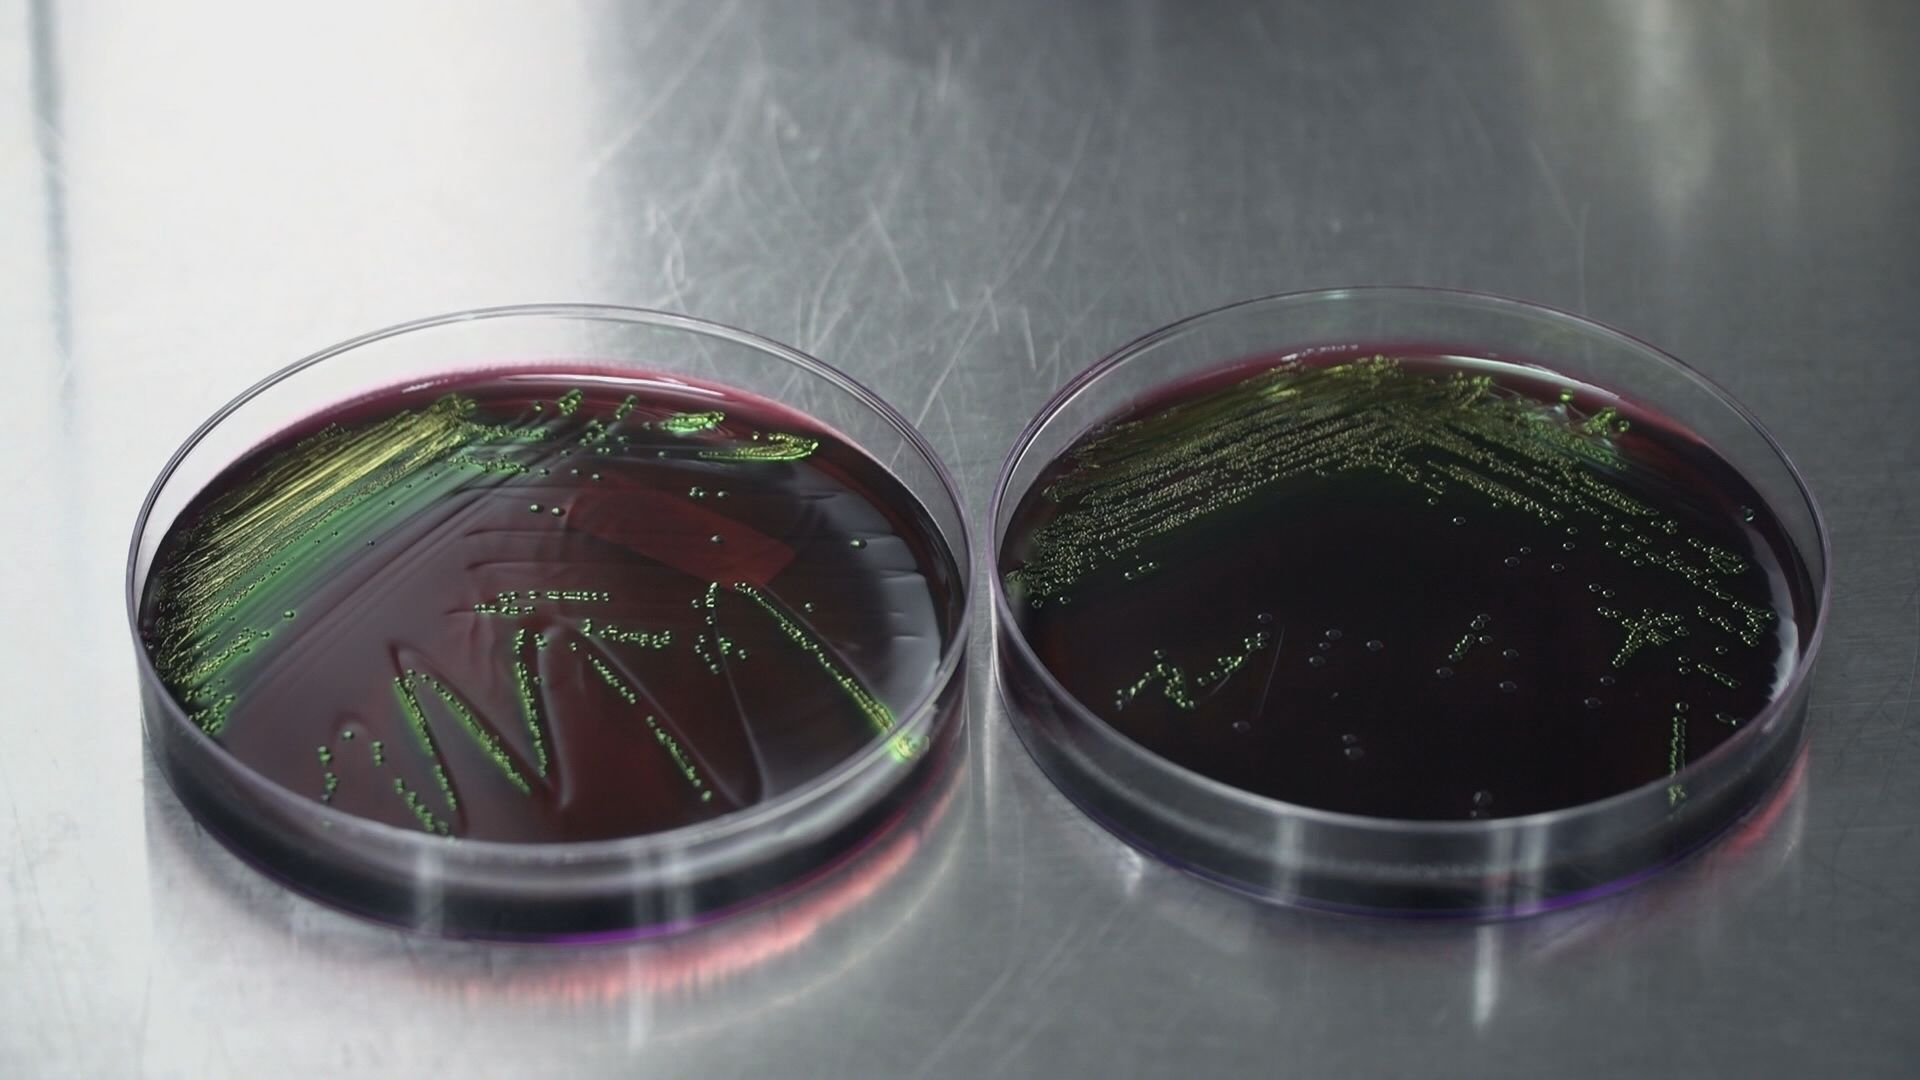

분야별 뉴스 - 생활문화
-
질병관리청, 수인성 식품 매개 감염병 주의 당부
질병관리청은 추석 연휴 기간 기온과 습도가 높아 수인성, 식품 매개 감염병 발생 우려가 크다며 주의를 당부했습니다.질병관리청은 "2022년 살모넬라균 감염증이 과거 5년 평균보다 20% 가까이 늘고 있다"며 "계란 표면에 살모넬라균이 있을 수 있어서 계란을 만진 후에 손을 씻고 식재료 냉장 보관 등에 주의해야 한다"고...
김철우 2022년 09월 08일 -

국립공원공단, 추석 연휴 가을 야생화 꽃길 21곳 소개
국립공원공단은 추석 연휴 가족들과 함께 방문할만한 '국립공원 야생화 꽃길' 21곳을 선정했습니다.주왕산 계곡 길과 소백산 연화봉길, 경주 암곡길 등 가을철 야생화를 볼 수 있는 길입니다.국립공원공단은 추석 다음 날인 11일부터는 소백산 2곳 등 전국 국립공원 6곳의 8개 구간에서 야생화 해설과 체험을 할 수 있는 가...
김철우 2022년 09월 08일 -

대구·경북 추석 연휴 맑고 화창···일교차 유의
◀앵커▶이번 추석 연휴 기간에는 맑고 화창한 가을 날씨가 이어질 것으로 전망됩니다.추석 당일에는 환한 보름달도 볼 수 있겠습니다.추석 연휴 대구·경북의 날씨. 유하경 기상캐스터가 전해드립니다. ◀기상캐스터▶‘더도 말고 덜도 말고 늘 한가위만 같아라.’이 속담은 매일 추석처럼 즐겁고 풍성하게 보냈으면 하는 의미를 ...
유하경 기상캐스터 2022년 09월 08일 -

[약손+] 류마티스관절염② 무릎 만졌는데 따뜻하다면?
퉁퉁 부어오른 손발, 쿡쿡 쑤시는 뼈마디, 단순한 관절의 문제가 아닐 수도 있습니다. 내 몸이 나를 공격하는 자가 면역 질환인 류마티스 관절염의 증상일 수 있는데요, 한번 굳으면 되돌릴 수 없어서 '관절의 암'이라고 불리기도 합니다. 류마티스 관절염의 증세는 어떤 것이고 어떻게 치료할 수 있는지 계명대학교동산병...
윤영균 2022년 09월 08일 -

대구·경북 맑고 일교차 큰 날씨 지속··· "추석, 구름 사이 보름달"
절기상 백로인 9월 8일 대구·경북은 맑은 가운데 일교차가 크겠습니다. 아침 최저기온은 대구 15.1, 구미와 안동 14.3, 포항 16.8도 등 전날과 비슷하거나 조금 낮습니다.낮 최고기온은 대구 29도 등 25도에서 29도로 전날과 비슷하겠습니다.아침까지 경북 내륙에는 가시거리 1km 미만의 안개가 끼는 곳이 있겠습니다.추석 ...
도건협 2022년 09월 08일 -

이슬이 맺히는 절기 ‘백로’…오늘도 맑고 화창
오늘(8일)은 '이슬이 맺히기 시작'한다는 절기 '백로'입니다.대개 '백로'가 지나면, 가을이 본격적으로 시작하는 시기라고 하는데요. 최근 맑게 드러난 청명한 하늘을 바라보면, 가을기운을 물씬 느낄 수 있습니다. 다만 이 때쯤 밤 기온이 급격히 내려가 안개가 자주 끼는데요. 오늘(8일)도 아침까지는 경북내륙을 중심으...
유하경 기상캐스터 2022년 09월 08일 -

[약손+] 류마티스관절염① 상류층이 많이 걸리던 병?
류마티스 관절염, 암이 뼈에 전이된 것에 못지않을 정도로 통증 심해···르누아르, 프랭클린, 제퍼슨, 미켈란젤로 등 유명 화가·정치가·배우·이집트 황제 등 류마티스로 고생해퉁퉁 부어오른 손발, 쿡쿡 쑤시는 뼈마디, 단순한 관절의 문제가 아닐 수도 있습니다. 내 몸이 나를 공격하는 자가 면역 질환인 류마티스 관절염의...
윤영균 2022년 09월 07일 -

당분간 맑은 날씨 이어져…일교차 유의
태풍 '힌남노'의 영향으로 크고 작은 피해가 많이 발생했습니다.어제 오후 태풍은 동해상으로 물러났고요. 5일부터 어제까지 내린 비의 양은 대구 112.8mm, 피해가 컸던 포항은 500mm 이상의 물 폭탄이 쏟아졌습니다. 이제는 비구름이 걷히고 다시 평온한 날씨를 되찾았습니다. 어제부터 파란 하늘이 드러난 곳이 많았는데...
유하경 기상캐스터 2022년 09월 07일 -

[약손+] 노인우울증⑩ 갑자기 생긴 의처증, 우울증 때문?
세계보건기구에서는 인류에게 가장 부담을 주는 10가지 질환을 꼽았는데 그중 3위가 우울증이었습니다. 2030년에는 이 우울증이 1위를 차지할 것이라는 예측까지 냈습니다. '마음의 감기'라고 불리는 우울증, 이 우울증 환자 10명 중 4명은 노인이라고 합니다. 노인 우울증은 왜 생기는지, 어떤 증상이 있고 어떻게 극복해...
윤영균 2022년 09월 06일 -

경북, 유형문화재 4건·문화재 자료 2건 지정
경상북도가 유형문화재 4건과 문화재 자료 2건을 지정했습니다.이번에 지정한 4건의 경북 유형문화재는 포항 원법사에 있는 사리불아비담론 권제30, 아비달마대비바사론 권제20, 육경합부, 퇴계 선생 수묵입니다.문화재 자료 2건은 구미 죽장리 이정표석과 구황촬요입니다.경상북도 문화재위원회는 이와 함께 경주 방어리 ...
서성원 2022년 09월 06일